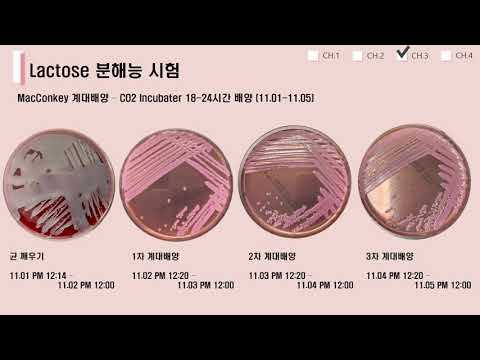

✨bap배지: 당신의 개성을 빛낼 최고의 선택! 나만의 특별한 뱃지를 만들어보세요! ✨
작성자 정보
- bap배지 작성
- 작성일
컨텐츠 정보
- 45 조회
- 목록
본문
이 게시물에는 제휴 링크가 포함되어 있으며, 구매 시 저에게 수익이 지급됩니다.
bap배지를 찾고 계신가요? 개성 넘치는 디자인부터 실용적인 기능까지, bap배지가 당신의 기대를 뛰어넘을 것입니다. 이 글에서는 bap배지에 대한 모든 것을 자세히 알려드립니다.
bap배지 핵심정보 요약
특징 | 상세 정보 |
---|---|
재질 | 고급 아크릴, 금속, 에폭시 등 다양한 선택 가능 |
디자인 | 자유로운 디자인 제작, 개인 맞춤형 제작 지원 |
사이즈 | 다양한 사이즈 (소형부터 대형까지) 선택 가능 |
용도 | 옷, 가방, 모자 등 다양한 소품 부착 가능 |
주문방법 | 온라인 주문, 간편한 디자인 업로드 및 주문 시스템 |
bap배지는 무엇일까요?
bap배지는 단순한 액세서리가 아닙니다. 개인의 취향과 개성을 표현하는 특별한 수단이자, 소중한 추억을 담는 기념품입니다. 고품질의 소재와 정교한 제작 기술로 완성된 bap배지는 뛰어난 내구성과 아름다운 디자인을 자랑합니다. 자신만의 디자인으로 제작하거나, 다양한 기성 디자인 중 선택할 수 있어 더욱 특별한 bap배지를 소유할 수 있습니다. 학교, 동호회, 기업 등 다양한 곳에서 활용되고 있으며, 최근에는 개인의 개성을 드러내는 패션 아이템으로도 인기를 얻고 있습니다.
어떤 종류의 bap배지가 있을까요?
bap배지는 재질, 디자인, 크기 등 다양한 종류가 있습니다.
재질 | 특징 | 예시 |
---|---|---|
아크릴 | 가볍고 다채로운 색상 표현이 가능합니다. | 투명 아크릴, 유색 아크릴, 우유빛 아크릴 |
금속 | 고급스럽고 내구성이 뛰어납니다. | 금속, 은색, 구리 등 다양한 금속 소재 |
에폭시 | 3D 입체 디자인 표현이 가능합니다. | 볼륨감 있는 캐릭터, 로고 등 |
디자인 유형 | 특징 | 예시 |
---|---|---|
캐릭터 디자인 | 귀엽고 개성 넘치는 캐릭터를 활용한 디자인입니다. | 애니메이션 캐릭터, 동물 캐릭터, 오리지널 캐릭터 등 |
로고 디자인 | 기업이나 단체의 로고를 활용한 디자인입니다. | 회사 로고, 학교 로고, 동호회 로고 등 |
사진 디자인 | 개인 사진이나 그림을 활용한 디자인입니다. | 가족사진, 반려동물 사진, 풍경 사진 등 |
텍스트 디자인 | 원하는 문구를 새겨 넣은 디자인입니다. | 이름, 슬로건, 명언 등 |
bap배지 제작은 어떻게 하나요?
bap배지 제작은 매우 간편합니다. 온라인 주문 시스템을 통해 원하는 디자인을 업로드하고, 크기, 재질, 수량 등을 선택하면 됩니다. 디자인 전문가의 도움을 받아 더욱 완성도 높은 bap배지를 제작할 수도 있습니다. 주문 후에는 제작 과정을 실시간으로 확인할 수 있으며, 빠르고 안전하게 배송받을 수 있습니다.
bap배지 최신 트렌드는 무엇일까요?
최근 bap배지 트렌드는 개인 맞춤형 디자인과 친환경 소재 사용으로 나타납니다. 특히, 자신만의 사진이나 그림을 활용하여 세상에 하나뿐인 bap배지를 제작하는 것이 인기입니다. 또한, 재활용 가능한 친환경 소재를 사용하는 bap배지에 대한 수요가 늘고 있습니다.
bap배지, 어디에 사용할 수 있을까요?
bap배지는 활용도가 무궁무진합니다. 옷, 가방, 모자 등 다양한 소품에 부착하여 나만의 개성을 표현할 수 있습니다. 또한, 학교, 동호회, 기업 등에서 기념품이나 홍보용품으로 활용하기에도 좋습니다. 특히 최근에는 캠핑이나 여행 등의 활동에서 개인 소지품에 bap배지를 부착하여 개성을 드러내는 것이 유행하고 있습니다.
bap배지, 구매는 어디서 할 수 있나요?
저희 웹사이트에서 간편하게 bap배지를 주문하실 수 있습니다. 다양한 디자인과 옵션을 선택하고, 원하는 수량을 입력하여 주문하시면 됩니다. 고객센터를 통해 문의사항을 남겨주시면 친절하게 상담해 드리겠습니다.
결론: 당신의 이야기를 담은 bap배지, 지금 바로 제작해보세요!
bap배지는 단순한 액세서리를 넘어, 당신의 개성과 이야기를 담는 특별한 아이템입니다. 지금 바로 저희 웹사이트를 방문하여 나만의 bap배지를 제작해보세요! 후회하지 않으실 겁니다.
상품상세보기 : bap배지 상품 비교, 할인정보 바로가기
로그인 후 bap배지에 대한 FAQ를 등록해 주세요.
네이버백과 검색 네이버사전 검색 위키백과 검색
bap배지 관련 동영상

bap배지 관련 상품검색
관련자료
-
이전
-
다음